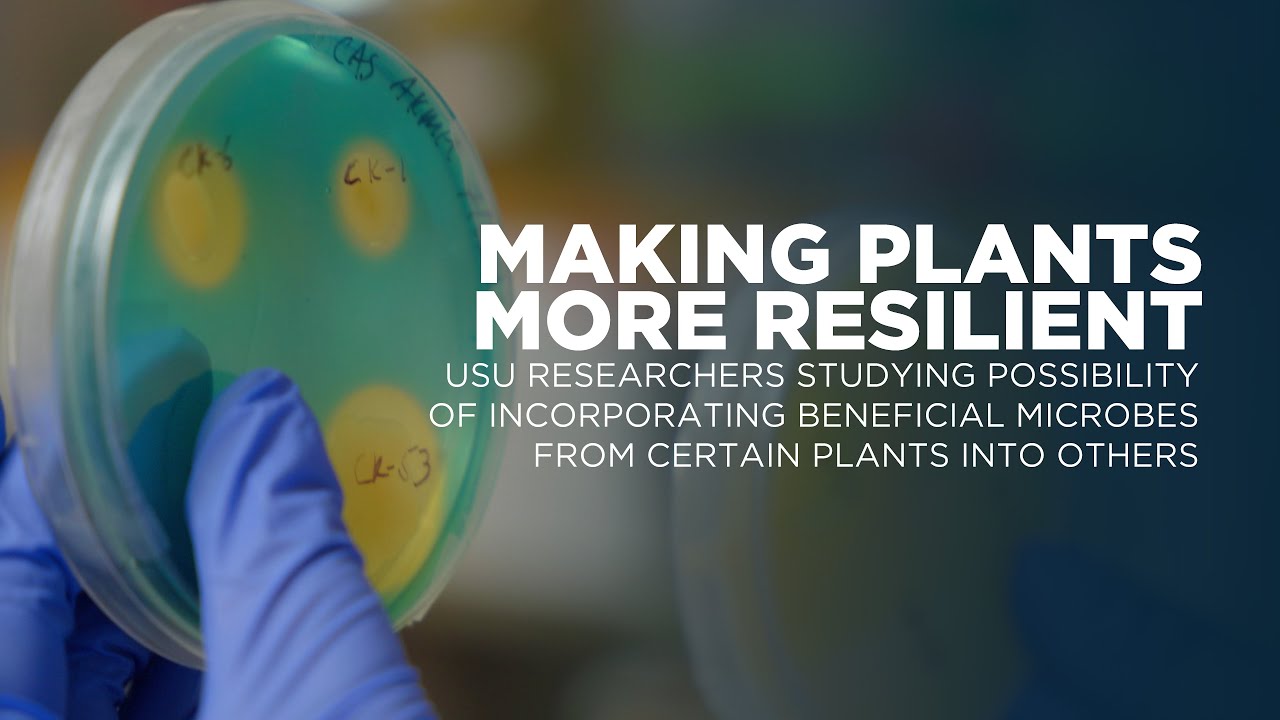

Usu Academic Calendar 2024-25 – However, with this new legislation, the application window will now open in December 2023 for the 2024-25 academic year. Utah State University encourages all students to submit their FAFSAs as soon as . Here is the direct link to it. The programmes for which DU has released the academic calendar 2024 are: As per the released schedule, classes for Semester 1 will begin from November 20 .
Usu Academic Calendar 2024-25
Source : www.usu.edu
InTech Academy Commences Enrollment for the 2024 25 Academic Year
Source : intechacademy.org
FAFSA Application Simplified, Applications for 2024 25 to Open in
Source : www.usu.edu
Utah State University Southwest
Source : www.facebook.com
FAFSA Application Simplified, Applications for 2024 25 to Open in
Source : www.usu.edu
Congratulations GHS Artists
Source : schools.graniteschools.org
Utah State University: Pioneering Online Education for 25 Years
Source : www.usu.edu
USU Studying Possibility of Incorporating Beneficial Microbes From
Source : www.usu.edu
Utah State University: Pioneering Online Education for 25 Years
Source : www.usu.edu
Home SHPE
Source : shpe.org
Usu Academic Calendar 2024-25 FAFSA Application Simplified, Applications for 2024 25 to Open in : Delhi University has released an academic calendar 2024 for MA courses in Hindu Studies, Korean and Chinese and for BA LLB (Hons), BBA LLB (Hons), and other courses. As per the released schedule . (Courtesy McKinney ISD) McKinney ISD students can expect school days to be three minutes longer in the 2024-25 school year. The MISD board of trustees approved the academic calendar in a 4-0 vote .